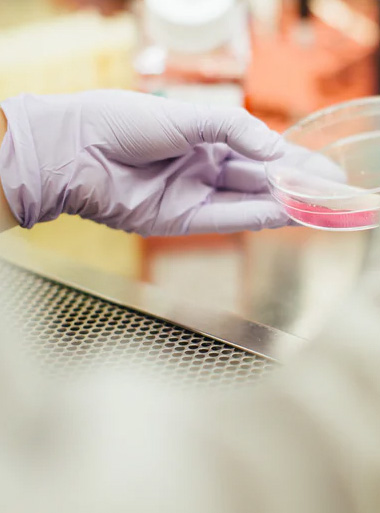
LabFlox

Our qualified and ardent team of technologists provide strong support
Our qualified and ardent team of technologists provide strong support
Our qualified and ardent team of technologists provide strong support
Our qualified and ardent team of technologists provide strong support

Our qualified and ardent team of doctors and
technologists provide strong support Interactively coordinate
proactive e-commerce via proces-centric outside the box thinking.


Laboflex is full and all encompassing, covering Clinical Pathology, Cytopathology, Clinical chemistry, Genetics.

Laboflex is full and all encompassing, covering Clinical Pathology, Cytopathology, Clinical chemistry, Genetics.

Laboflex is full and all encompassing, covering Clinical Pathology, Cytopathology, Clinical chemistry, Genetics.
